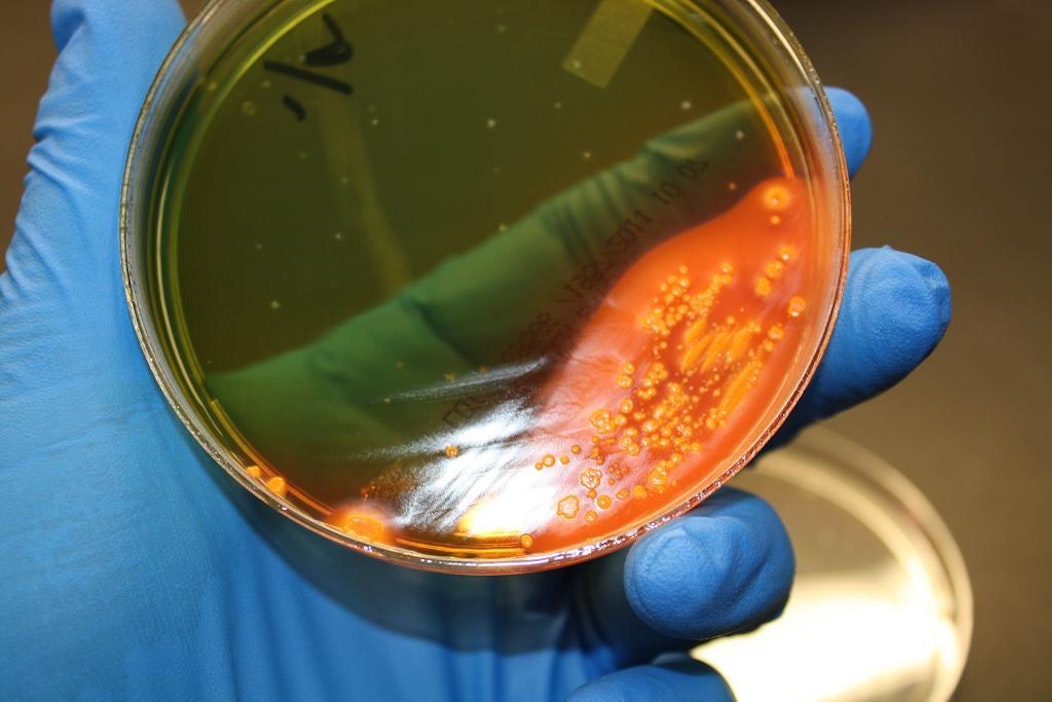

48 miljoonaa amerikkalaista sairastuu ruuasta joka vuosi
Ruokaperäisten sairastumisien hinta on 15,1 miljardia euroa vuodessa. E.coli-bakteeri on aiheutanut viime ja tänä vuonna neljä usean osavaltion alueelle levinnyttä epidemiaa. Kuvassa e.colin kasvualusta laboratoriossa. Kuva: Flickr VeeDunn
E.coli-bakteeri on aiheutanut viime ja tänä vuonna neljä usean osavaltion alueelle levinnyttä epidemiaa. Kuvassa e.colin kasvualusta laboratoriossa. Kuva: Flickr VeeDunn48 miljoonaa, eli noin kuudesosa, amerikkalaisista sairastuu ruuasta peräisin oleviin tauteihin vuodessa. 128 000 joutuu sairaalaan ja 3 000 kuolee, selviää USA:n maatalousbudjetista.
Kyse on mikrobien saastuttamista ruuista. Yleisimmät taudinaiheuttajat ovat listeria, salmonella ja e.coli.
USA:n maataloushallinto USDA arvioi sairastumisien kustannukseksi 15,1 miljardia dollaria.
Ruokaturvallisuudesta vastaava CDC muistuttaa, että taudit ovat mahdollisia välttää. CDC on viranomainen, jonka tehtävä on pysäyttää useisiin osavaltioihin levinneiden epidemioiden leviäminen. Tänä vuonna se on puuttunut kahteen saastuneen ruuan aiheuttamaan epidemiaan.
Listeriaa sisältänyttä pehmeää juustoa levisi alkuvuonna neljään osavaltioon. Kuusi sairastui, joista kaksi kuoli. Muut joutuivat sairaalaan.
Soijapähkinävoin e.coli bakteeri sairastutti 23 henkilöä yhdeksässä osavaltiossa. Kymmenen joutui sairaalaan.
Viime vuonna epidemioita oli 13.
Tautien määrä on laskussa. Vuonna 2015 ruuan tarkastuksista vastaavan viranomaisen FSIS:n mukaan vuonna 2015 sairastumisia oli 11 prosenttia vähemmän kuin vuonna 2009. Esimerkiksi salmonellan esiintymistä rajoittavia sääntöjä on tehostettu.
FSIS:n budjetti ensi vuonna on noin 1,2 miljardia euroa. Summalla noin 8 000 tarkastajaa tekee työtä noin 6 400 teurastamolla ja laitoksella.
Artikkelin aiheet- Osaston luetuimmat
